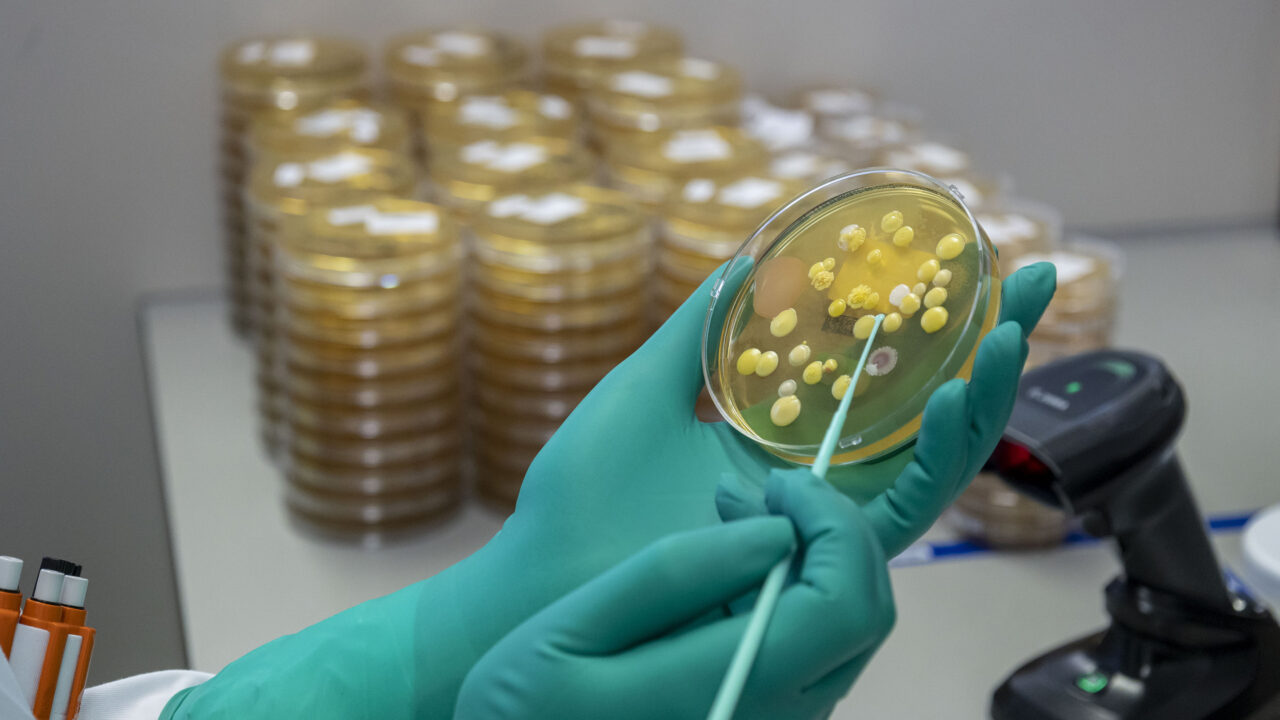

Werken bij Organon
Organon is een wereldwijd gezondheidsbedrijf dat zich richt op een beter en gezonder leven voor vrouwen. Organon is in 2021 officieel gestart als nieuw bedrijf op het gebied van vrouwengezondheid na een spin-off van Merck & Co, bekend als MSD buiten de Verenigde Staten en Canada. Een nieuw bedrijf met bijna honderd jaar ervaring in Nederland.
De focus van Organon is het verbeteren van de gezondheid van vrouwen gedurende hun hele leven. Hiervoor heeft het bedrijf meer dan zestig geneesmiddelen en producten op verschillende therapeutische gebieden. Om een gezondere wereld te bereiken, vindt Organon het van cruciaal belang om de gezondheid van vrouwen te verbeteren. De helft van de wereldbevolking bestaat immers uit vrouwen. Als nieuw bedrijf luisteren ze naar de gezondheidsbehoeften van vrouwen, om zo de productontwikkeling te stimuleren en nieuwe oplossingen te creëren en te leveren. De impact van Organon zal verder gaan dan geneesmiddelen, anticonceptie en vruchtbaarheidsbehandelingen, omdat er nog zoveel meer gedaan kan worden.
“ Kom vooral bij Organon werken als je wilt dat je werk bijdraagt aan een betere wereld (voor vrouwen), en als je daarnaast je eigen ontwikkeling belangrijk vindt en mee wilt groeien met de verdere ontwikkeling van ons bedrijf. ”
- Productielocaties Benelux in Oss en Heist-op-den-Berg
- Kantoren Benelux in Amsterdam en Brussel
- Hoofdkantoor in New Jersey
- 2.000 werknemers in Benelux
- 9.000 werknemers wereldwijd
- Actief in meer dan 140 landen
- 45% / 55%
- Gem. leeftijd 46 jaar

Ontwikkelen binnen de organisatie
Binnen Organon zijn er diverse manieren om jezelf als medewerker te ontwikkelen. Dit kan door middel van trainingen via Goodhabitz en via diverse interne en externe trainingen.
Waarom werken bij Organon
Geen vacatures bij Organon
Op dit moment zijn er geen vacatures bij dit bedrijf.
Wat is onze grootste uitdaging?
Organon staat voor de uitdaging om de productontwikkeling te stimuleren en nieuwe oplossingen te creëren en te leveren voor een wereldwijde betere gezondheid van vrouwen. Dit begint met luisteren naar de gezondheidsbehoeften van vrouwen. We werken eraan om innovatieve geneesmiddelen en producten toegankelijk te maken voor de patiënten die ze nodig hebben.
‘Streven naar een beter en gezonder leven voor elke vrouw. Wij geloven dat vrouwen de basis vormen voor een gezondere wereld.’
Organon






